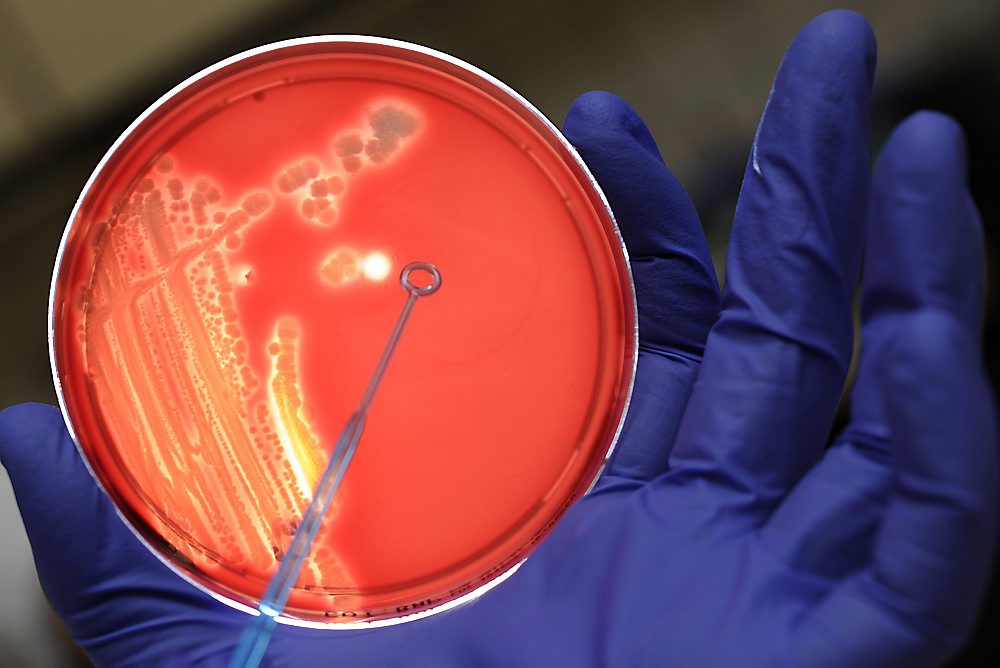

Tot dusver was het jongste slachtoffer 20 jaar, aldus gegevens van het nationale gezondheidscentrum Robert Koch Institut. Het totale dodental in Duitsland komt daarmee op 36, in Europa ligt dat op 37.
In het gezin van de peuter is ook de 10-jarige broer en de vader ziek door de EHEC-bacterie. Zij zijn inmiddels aan de beterende hand, aldus artsen.